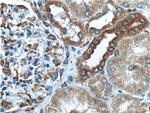
SYVN1 Antibody in Immunohistochemistry (Paraffin) (IHC (P))

Search
Proteintech
SYVN1 Polyclonal Antibody
{{$productOrderCtrl.translations['antibody.pdp.commerceCard.promotion.promotions']}}
{{$productOrderCtrl.translations['antibody.pdp.commerceCard.promotion.viewpromo']}}
{{$productOrderCtrl.translations['antibody.pdp.commerceCard.promotion.promocode']}}: {{promo.promoCode}} {{promo.promoTitle}} {{promo.promoDescription}}. {{$productOrderCtrl.translations['antibody.pdp.commerceCard.promotion.learnmore']}}
产品信息
13473-1-AP
种属反应
已发表种属
宿主/亚型
分类
类型
抗原
偶联物
形式
浓度
规格
纯化类型
保存液
内含物
保存条件
运输条件
产品详细信息
Immunogen sequence: LFAIRPMYL AMRQFKKAVT DAIMSRRAIR NMNTLYPDAT PEELQAMDNV CIICREEMVT GAKRLPCNHI FHTSCLRSWF QRQQTCPTCR MDVLRASLPA QSPPPPEPAD QGPPPAPHPP PLLPQPPNFP QGLLPPFPPG MFPLWPPMGP FPPVPPPPSS GEAVAPPSTS AAALSRPSGA ATTTAAGTSA TAASATASGP GSGSAPEAGP APGFPFPPPW MGMPLPPPFA FPPMPVPPAG FAGLTPEELR ALEGHERQHL EARLQSLRNI HTLLDAAMLQ INQYLTVLAS LGPPRPATSV NSTEETATTV VAAASSTSIP SSEATTPTPG ASPPAPEMER PPAPESVGTE EMPEDGEPDA AELRRRRLQK LESPVAH (242-617 aa encoded by BC030530 )
靶标信息
HRD1 is a ubiquitin ligase whose expression is induced by the unfolded protein response (UPR) following endoplasmic reticulum stress. Expression of HRD1 protects cells from apoptosis by inducing degradation of abnormally processed proteins that accumulate in the endoplasmic reticulum. HRD1 is expressed in many tissues, strongly expressed in brain, pancreas, liver, kidney and skeletal muscle. It has been reported that Synoviolin/Hrd1 (expressed in rheumatoid synovium) is a novel causative factor for arthropathy by triggering synovial cell outgrowth through its anti-apoptotic effects. HRD1 contains one ring-type zinc finger.
仅用于科研。不用于诊断过程。未经明确授权不得转售。
生物信息学
蛋白别名: E3 ubiquitin-protein ligase synoviolin; HMG-coA reductase degradation 1 homolog; HRD1 protein; MGC40372; required for ER protein degradation; RING-type E3 ubiquitin transferase synoviolin; Synovial apoptosis inhibitor 1; synovial apoptosis inhibitor 1, synoviolin; synoviolin 1; unnamed protein product
基因别名: 1200010C09Rik; AW211966; C85322; D530017H19Rik; DER3; HRD1; KIAA1810; RGD1310488; SYVN1
UniProt ID: (Human) Q86TM6, (Mouse) Q9DBY1
Entrez Gene ID: (Human) 84447, (Mouse) 74126, (Rat) 361712